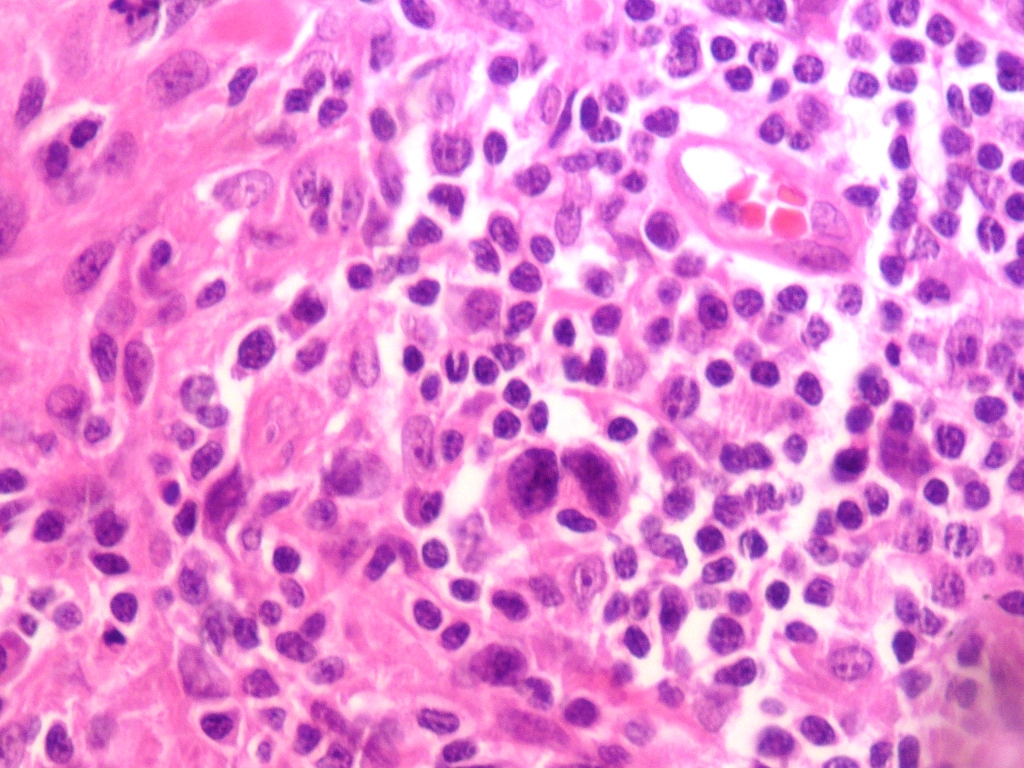

- Coordenador: Francisco Alves de Araújo Junior
- Coordenador: RENATO BARDELLI DOS SANTOS NETO
- Coordenador: FRANCISCO BERALDI DE MAGALHAES
- Coordenador: Adriana Buechner de Freitas Brandão
- Coordenador: JULIO CESAR FOIATTO
- Coordenador: Maria Cristina Silva Montenegro Correa
- Coordenador: Luciana de Paula Souza
- Coordenador: Mirella Ferreira Santos
- Coordenador: Wilton Francisco Gomes
- Coordenador: Bruno Granja Marcos
- Coordenador: Alexandra Ingrid dos Santos Czepula
- Coordenador: MATHEUS KAHAKURA FRANCO PEDRO
- Coordenador: Alexandre Leal Laux
- Coordenador: Flavio Meingast Piva
- Coordenador: Vanessa Cristine Ribeiro Fredrich
- Coordenador: Maiara Silva Tramonte
- Coordenador: Livia Sissi Piechnik
- Professor Autor: Rafaela Pires Erthal Michelato
- Coordenador: FRANCISCO BERALDI DE MAGALHAES
- Coordenador: Adriana Buechner de Freitas Brandão
- Coordenador: Mirella Ferreira Santos
- Coordenador: Livia Sissi Piechnik
- Professor Autor: Alexandra Ingrid dos Santos Czepula
- Professor Autor: BETINA MENDEZ ALCÂNTARA GABARDO
- Coordenador: FRANCISCO BERALDI DE MAGALHAES
- Coordenador: Adriana Buechner de Freitas Brandão
- Coordenador: Leonardo Campos Teixeira
- Coordenador: Mirella Ferreira Santos
- Coordenador: Livia Sissi Piechnik
- Coordenador: FRANCISCO BERALDI DE MAGALHAES
- Coordenador: Adriana Buechner de Freitas Brandão
- Coordenador: Mirella Ferreira Santos
- Coordenador: Livia Sissi Piechnik
- Professor Autor: NATALIA DE OLIVEIRA REGO FREIRE
- Professor Autor: BETINA MENDEZ ALCÂNTARA GABARDO
- Professor Autor: Isabella Moraes Rocha
- Professor Autor: Karolina Perbiche dos Santos
- Professor Autor: Myrella Rocha Mattar
- Professor Autor: Leandro Rozin
- Professor Autor: Mariana Turra

- Coordenador: FRANCISCO BERALDI DE MAGALHAES
- Coordenador: Adriana Buechner de Freitas Brandão
- Coordenador: Mirella Ferreira Santos
- Coordenador: Livia Sissi Piechnik
- Professor Autor: Henrique Alexandre Stachon
- Professor Autor: João Claudio Campos Pereira
- Professor Autor: Newton Carvalhal Santos Junior
- Professor Autor: HENRIQUE DE AGUIAR WIEDERKEHR
- Professor Autor: Edimar Leandro Toderke
- Coordenador: FRANCISCO BERALDI DE MAGALHAES
- Coordenador: Adriana Buechner de Freitas Brandão
- Coordenador: Mirella Ferreira Santos
- Coordenador: Livia Sissi Piechnik
- Professor Autor: Francisco Alves de Araújo Junior
- Professor Autor: RENATO BARDELLI DOS SANTOS NETO
- Professor Autor: JULIO CESAR FOIATTO
- Professor Autor: Maria Cristina Silva Montenegro Correa
- Professor Autor: Luciana de Paula Souza
- Professor Autor: Wilton Francisco Gomes
- Professor Autor: Bruno Granja Marcos
- Professor Autor: Alexandra Ingrid dos Santos Czepula
- Professor Autor: MATHEUS KAHAKURA FRANCO PEDRO
- Professor Autor: Alexandre Leal Laux
- Professor Autor: Flavio Meingast Piva
- Professor Autor: Rafaela Pires Erthal Michelato
- Professor Autor: Vanessa Cristine Ribeiro Fredrich
- Professor Autor: Maiara Silva Tramonte
- Coordenador: Francisco Alves de Araújo Junior
- Coordenador: RENATO BARDELLI DOS SANTOS NETO
- Coordenador: FRANCISCO BERALDI DE MAGALHAES
- Coordenador: Adriana Buechner de Freitas Brandão
- Coordenador: JULIO CESAR FOIATTO
- Coordenador: Maria Cristina Silva Montenegro Correa
- Coordenador: Luciana de Paula Souza
- Coordenador: Mirella Ferreira Santos
- Coordenador: Wilton Francisco Gomes
- Coordenador: Bruno Granja Marcos
- Coordenador: Alexandra Ingrid dos Santos Czepula
- Coordenador: MATHEUS KAHAKURA FRANCO PEDRO
- Coordenador: Alexandre Leal Laux
- Coordenador: Flavio Meingast Piva
- Coordenador: Vanessa Cristine Ribeiro Fredrich
- Coordenador: Maiara Silva Tramonte
- Coordenador: Livia Sissi Piechnik
- Professor Autor: Rafaela Pires Erthal Michelato